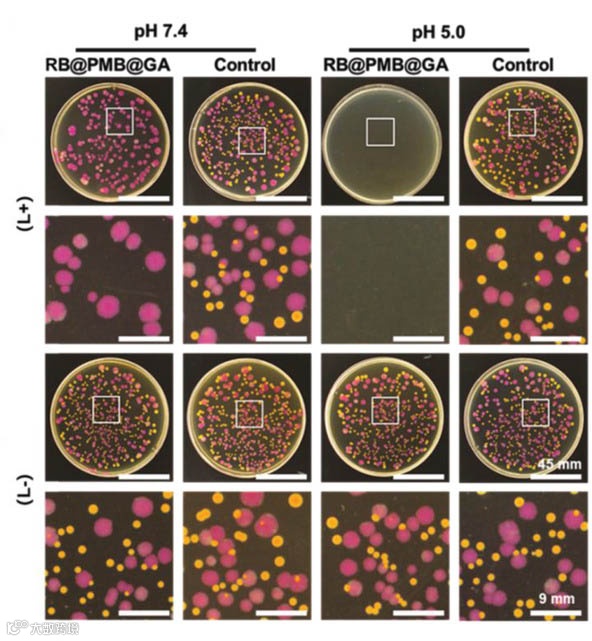

细菌可以附着在植入的医疗设备上形成生物膜,从而导致持续感染甚至患者死亡,对公众健康造成严重威胁。现有对抗生物膜的最常见方法是增加抗生素的使用剂量。然而,过度使用抗生素会导致耐药菌的产生。因此,开发一种生物膜敏感的新型生物膜杀伤策略迫在眉睫。
光动力疗法(PDT)在治疗细菌引起的生物膜感染方面具有巨大的应用潜力。但是革兰氏阴性菌的外膜和带高负电荷的脂质部分阻碍了光敏剂与细菌的有效结合,这导致了PDT对革兰氏阴性菌的杀伤效率不高。现有的解决方法是将PS与阳离子聚合物或阳离子抗菌肽相结合。阳离子光活性纳米粒子(NPs)通过与的细菌结合,不仅可以提高革兰氏阴性菌对PDT的敏感性,还可以增强生物膜渗透和根除。然而,带正电荷的纳米颗粒对正常的哺乳动物细胞存在潜在毒性。
针对正电荷纳米颗粒存在的潜在毒性,徐福建教授团队引入了pH响应的概念,如图1所示,以电荷逆转为策略设计了具有低细胞毒性和高抗菌活性的功能适应性纳米颗粒RB@PMB@GA NPs。RB@PMB@GA NPs在生理条件下(pH 7.4)是负电性的,减少了细胞内吞,对正常细胞的毒性最小。由于细菌代谢物的存在,感染部位通常是酸性微环境,pH范围为5.0 - 6.5。RB@PMB@GA NPs在酸性相关感染部位由于质子作用使得葡萄糖酸(GA)脱落,转换为正电性的纳米颗粒RB@PMB NPs,可以有效地结合到带负电的细菌表面,从而增强了对革兰氏阴性菌的光动力抗菌作用。

图1. 用于增强生物膜渗透和抗菌效率的光动力纳米颗粒的制备过程示意图。
本研究首先选择了革兰氏阴性菌(大肠杆菌,红色)和革兰氏阳性菌(金黄色葡萄球菌,黄色)来测试RB@PMB@GA NPs的光动力抗菌能力。图2的结果表明,相对于革兰氏阳性菌,革兰氏阴性菌比PDT更不敏感。但是在酸性环境下,RB@PMB@GA NPs 的电荷反转能力提高了它们对革兰氏阴性菌的功效。
图2. RB@PMB@GA NPs在pH 7.4和pH 5.0条件下对大肠杆菌和的金黄色葡萄球菌的抗菌测试。
此外,本研究进一步检测了RB@PMB@GA NPs对生物膜的渗透杀伤性能。如图3所示,在7.4和5.0的pH值下RB@PMB NPs能有效渗透到生物膜内。然而,在pH 7.4的生物膜中仅检测到 RB@PMB@GA NPs 的非常微弱的红色荧光,在pH 5.0时RB@PMB@GA NPs能渗透到生物膜底部。因为 RB@PMB@GA NPs在酸性微环境脱落GA带正电,与带负电细菌表面发生静电相互作用而迅速渗入生物膜并根除生物膜。这些结果也通过在体内小鼠模型中植入导管得到了证明,这为消除医疗器械上的生物膜提供了一种很有前景的方法。

图3. 在不同pH值下用RB@PMB和RB@PMB@GA NPs处理的铜绿假单胞菌生物膜的CLSM图像。
最后,该团队选择植入的导管小鼠模型来证明RB@PMB@GA NPs在体内感染微环境激活的光动力抗菌效率。图4结果证实了RB@PMB@GA NPs光照情况下在体内具有良好的生物膜消除能力。

图4. a)第1、3和7天不同处理下小鼠的切口区域和植入导管的典型照片。b)从组织和导管中获得的细菌菌落的定量分析。
以上相关成果发表在Adv. Funct. Mater.2021, 2103591。论文的第一作者为北京化工大学材料科学与工程学院硕士研究生吴双梅,通讯作者为北京化工大学的徐福建教授和俞丙然教授,北京大学口腔医学院王宇光副教授。
论文链接:
https://pericles.periclesprod.literatumonline.com/doi/full/10.1002/adfm.202103591
相关进展
高分子科技原创文章。欢迎个人转发和分享,刊物或媒体如需转载,请联系邮箱:info@polymer.cn
诚邀投稿
欢迎专家学者提供稿件(论文、项目介绍、新技术、学术交流、单位新闻、参会信息、招聘招生等)至info@polymer.cn,并请注明详细联系信息。高分子科技®会及时推送,并同时发布在中国聚合物网上。
欢迎加入微信群 为满足高分子产学研各界同仁的要求,陆续开通了包括高分子专家学者群在内的几十个专项交流群,也包括高分子产业技术、企业家、博士、研究生、媒体期刊会展协会等群,全覆盖高分子产业或领域。目前汇聚了国内外高校科研院所及企业研发中心的上万名顶尖的专家学者、技术人员及企业家。
申请入群,请先加审核微信号PolymerChina (或长按下方二维码),并请一定注明:高分子+姓名+单位+职称(或学位)+领域(或行业),否则不予受理,资格经过审核后入相关专业群。
点
这里“阅读原文”,查看更多


